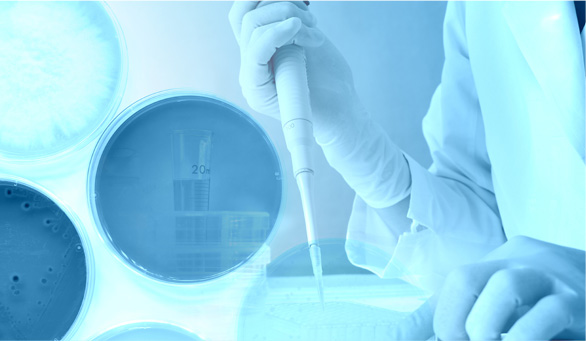
purified sodium hyaluronate

- Lauryl glycidyl ether
- trimethylolpropane triglycidyl ether
- Phosphate methacrylate
- Ammonium bifluoride
- Boric acid
- Hydrofluoric acid
- Hyaluronic acid fch
- Micro hyaluronic acid fch
- Bionanoceramide
- Biosphingo (glycosphingolipid)

- Gravinol kpa-cu
- Purified sodium hyaluronate
- Fluorescein
- Calcein-am
- Tetramethylrhodamine isotyhiocyanate
- Potassium iodide
- Tetrazole
- Triazole
- Azide
- Azidocarboxylic derivatives
- Isocyanates
- Thiophene
- Terpolymer silicone softener
- enzymes
- Acetyl bromide
- Butyryl bromide
- Pentafluorobenzene
- Tetrabromomethane
- Hexylthiophene
